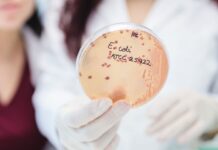

Колонка «Зворотній зв’язок», яка регулярно публікується в New Scientist, дає змогу поглянути зсередини на останні досягнення в науці та техніці, часто висвітлюючи химерне та несподіване. Цей епізод займає центральне місце на дивовижній відданості інтересам до хобі, від роботи штучного інтелекту, створеного в Minecraft, до повернення до аналогового керування завданнями.
Неймовірний ШІ в Minecraft: CraftGPT
Стаття висвітлює дивовижні зусилля YouTuber sammyuri, який створив велику мовну модель під назвою CraftGPT повністю в блочному світі Minecraft. Використовуючи Redstone — ігровий еквівалент електричних схем — Самміурі створив робочий штучний інтелект, здатний базово спілкуватися та відповідати на запити, як ChatGPT або Claude. Розмір проекту вражає: вражаючий дизайн із блоків редстоуну, що імітує компоненти LLM, включаючи токенізер, кеш KV і функцію лінійної активації (ReLU). Технічно це «модель малої мови» з 5 мільйонами параметрів, але її існування демонструє надзвичайну відданість справі та винахідливість. Прикладом розмови є «Привіт, як справи сьогодні?» «Сьогодні я почуваюся дуже щасливим, дякую, що запитали», — і самосвідоме визнання CraftGPT, що він — машина, підкреслює захопливий характер цього проекту.
Відставка президента і принадність аналога
Центр уваги повертається до світу ігор, знаменуючи відставку президента Nintendo America після десятиліття на чолі таких культових франшиз, як Mario. Випадковий збіг у відставку президента на ім’я Даг Боузер, який протистоять Черепасі Боузеру, створює момент грайливої іронії.
Потім у статті розглядається несподівана тенденція: відродження аналогового керування завданнями. «Аналоговий» менеджер справ від Ugmonk — по суті, картки та дерев’яний брусок — набуває популярності як альтернатива цифровим інструментам керування завданнями, залучаючи тих, хто прагне зосередитися офлайн і відпочити від соціальних мереж, які відволікають увагу. Стартовий набір коштує 75 фунтів стерлінгів плюс повторювані картки (близько 141 фунта стерлінгів на рік або місячна підписка), але Analog відповідає бажанням простоти та відразі до цифрового перевантаження. Ця тенденція підкреслює ширше бажання усвідомленої продуктивності та відновлення зв’язку з матеріальними інструментами.
Відданість, виявлена в цих, здавалося б, нішевих хобі, розкриває фундаментальне людське бажання творити, експериментувати та переслідувати інтереси, що виходять за рамки суто практичних потреб.
Нарешті, у статті самозвинувачується власна модель передплати журналу, нагадуючи нам, що навіть критичний аналіз існує в моделі передплати. Цьоготижневий епізод Feedback демонструє, що незалежно від того, чи йдеться про створення штучного інтелекту в Minecraft чи повернення до колекційних карток, відданість хобі може набувати напрочуд винахідливих, а іноді й неймовірно парадоксальних форм.